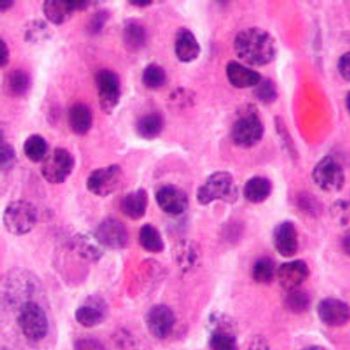

The FDA granted an accelerated approval of the CD-38-targeted monoclonal antibody daratumumab (Darzalex)-the first monoclonal antibody to be approved for patients with multiple myeloma.
The FDA granted an accelerated approval of the CD-38-targeted monoclonal antibody daratumumab (Darzalex)-the first monoclonal antibody to be approved for patients with multiple myeloma.
Many patients who have had melanoma do not conduct regular skin self-examinations, and those who do check themselves do not use sufficient tools or techniques.
The FDA has granted an accelerated approval for Tagrisso (osimertinib) to treat patients with advanced non–small cell lung cancer (NSCLC) positive the EGFR T790M mutation and whose disease worsened following a prior EGFR TKI.
Patients and practitioners can expect more personalized options for the treatment of polycythemia vera (PV), including more refined criteria for diagnosing symptomatic patients and identifying those at highest risk along with more therapies for treating a disease which carries a heavy symptom burden.
Despite growing interest in the financial burden of out-of-pocket cancer treatment costs, little is known about whether patients actually want to talk about costs with their oncology team.
Parenting a child with a life-threatening illness like cancer is associated with unique demands, but simultaneously raising healthy siblings can add yet another layer of complexity.
The FDA has approved Cotellic (cobimetinib) to be used in combination with Zelboraf (vemurafenib) to treat patients with metastatic or unresectable melanoma who carry the BRAFV600E/K mutation.
CancerCare, the leading national nonprofit organization providing free, professional support services to anyone affected by cancer, is pleased to announce the availability of co-payment assistance for pancreatic cancer patients through the CancerCare Co-Payment Assistance Foundation.
Patient engagement platform will provide support and empowerment while advancing blood cancer research
ASCO issues advice on NEPA for CINV.
For oncology practitioners fielding questions from patients and survivors about breast cancer or genetics research news they've read online or through social media, a recently-launched news and information rating resource hopes to make that process easier.
The incidence of oropharyngeal cancers is growing-now surpassing cervical cancer-and the increase is expected to continue over the next 30 years, particularly for men currently aged ≤40 years.
Despite its safeguarding purpose, a new study has found that nearly half of healthcare personnel contaminated themselves while removing personal protective equipment (PPE).
ASCO issues updated statement on its use and healthcare provider education.
Women at an elevated risk of breast cancer may be able to avoid preventive procedures with regular aerobic exercise, according to a new study published in Breast Cancer Research and Treatment.
Targeted agents, such as afatinib (Gilotrif) and erlotinib (Tarceva), ushered in a new paradigm for treating patients with non-small cell lung cancer (NSCLC) who have an EGFR mutation.
Accelerated partial breast irradiation (APBI) using multicatheter brachytherapy in patients with early-stage breast cancer was not inferior to conventional whole breast irradiation (WBI), according to a phase III study presented at the 2015 American Society for Radiation Oncology (ASTRO) Annual Meeting.
The FDA has expanded the approval of Yervoy (ipilimumab) to include adjuvant treatment of fully resected stage III melanoma. The treatment will apply to patients with pathologic involvement of regional lymph nodes >1 mm.
Rates are on the rise for both men and women.
The FDA has approved the first-in-class oncolytic viral therapy Imlygic (T-VEC; talimogene laherparepvec) for the local treatment of unresectable lesions of the skin and lymph nodes in patients with melanoma that recurred after initial surgery.
As a 9-year testicular cancer survivor, I know the value of health insurance coverage and I choose my plan very carefully.
A study published recently in the Journal of Geriatric Oncology found that as many as 1 in 4 senior oncology patients were using complementary or alternative medicines (CAM), and the authors note that few oncology clinicians are sufficiently aware of the alternative medicines their patients take.
Radiation-induced flares of bone pain were significantly reduced in patients with metastatic cancer with the addition of dexamethasone, according to research presented at the 2015 ASTRO Annual Meeting.
Contralateral prophylactic mastectomies (CPM) have been a growing trend among women at average risk of breast cancer with a diagnosis of cancer in one breast, but the procedure is not medically recommended for this population.
In her role as division head of Occupational & Environmental Medicine at the University of Maryland, Melissa A. McDiarmid, MD, MPH, spends a lot of her time working with individuals who have been occupationally or environmentally exposed to toxic substances..
Trabectedin (Yondelis) chemotherapy was approved by the FDA for treatment of patients with specific metastatic soft tissue sarcomas-liposarcoma and leiomyosarcoma-who previously received chemotherapy that included an anthracycline.
The FDA has approved MM-398, branded as Onivyde (irinotecan liposome injection) in combination with 5-fluorouracil (5-FU) chemotherapy and leucovorin for patients with metastatic pancreatic cancer. The treatment follows prior administration of a gemcitabine-based regimen.
Despite having significantly elevated risks of long-term health problems, many cancer survivors eat poorer-quality diets than the general population.
The American Cancer Society (ACS) has revised its breast cancer screening guidelines, recommending that women at an average risk of breast cancer receive a mammography annually starting at age 45-5 years later than previous recommendations formulated in 2003.
New evidence suggests that there may be a safe and effective treatment option for older patients with Hodgkin lymphoma who are ineligible for chemotherapy.